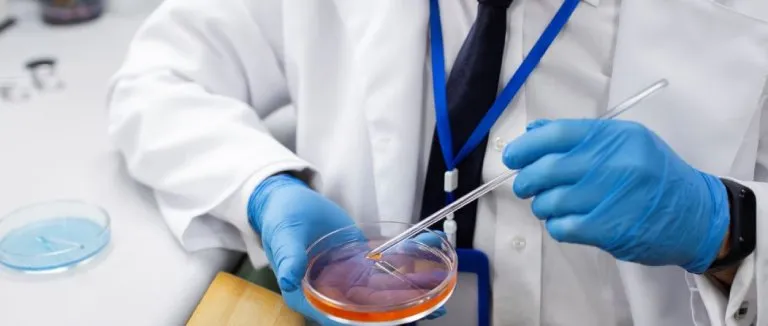
Kolera Nedir?

Kolera Nedir? Kolera Nasıl Bulaşır? Belirtileri ve Tedavisi

Son Güncelleme Tarihi 3.03.2026 09:50:57
Kolera, Vibrio cholerae adlı bakterinin neden olduğu, şiddetli ishal ve hızlı sıvı kaybıyla seyreden bulaşıcı bir bağırsak enfeksiyonudur. Tedavi edilmezse saatler içinde hayati sıvı ve elektrolit kaybına yol açabilir. Kirli su ve gıdalarla bulaşır; erken tanı, bol sıvı tedavisi ve uygun antibiyotik kullanımı ile kontrol altına alınabilir.
Kolera Nedir?
Kolera hastalığı genellikle kirli su ve kontamine gıdalar aracılığıyla bulaşır. Hastalık bulaşma kaynaklarına temas eden insanlar enfekte olma riski altındadır. Vücuda alınan Vibrio cholerae bakterileri ile enfeksiyonun ilk adımı gerçekleşir. Kolera bakterisi ince bağırsakta hızla çoğalmaya başlar. Burada, bakteriler bağırsak mukozasına bağlanarak kolera enfeksiyonunun temel mekanizmasını başlatırlar. Bakterilerin bağırsakta çoğalması sırasında kolera toksini adı verilen bir toksin üretilir. Bu toksin bağırsak hücrelerinin su ve tuz emilimini bozar, şiddetli ishale yol açar. Bu süreçte vücut büyük miktarda sıvı ve elektrolit kaybeder. Sıvı kaybı, dehidrasyona ve hastalığın şiddetli seyrine yol açabilir.
Kolera Nedenleri Nelerdir?
Kolera bazı özel risk faktörlerinin bir araya gelmesi sonucu ortaya çıkan bir bağırsak enfeksiyonudur. Koleraya neden olabilen risk faktörleri şunlardır:
- Hijyen ve Temiz Su Erişimi Yetersizliği: Temiz içme suyu ve uygun sanitasyon olmayan bölgelerde kolera riski daha yüksektir. Temiz su kaynaklarına sahip olamamak ve sağlık kurallarına uymamak enfeksiyonun yayılmasını kolaylaştırır.
- Kontamine Su ve Gıda Kaynakları: Kirli su kaynakları ve kontamine gıdalar aracılığıyla bulaşır. Kirli su kaynaklarının kullanılması veya hijyen kurallarına uyulmaması, hastalığın bulaşma riskini artırır. Aynı zamanda deniz ürünleri gibi kontamine gıdaların tüketilmesi de kolera riskini artırabilir.
- Kalabalık Ortamlar: Yoğun nüfusa sahip bölgelerde hijyen kurallarının uygulanması zorlaşır. Bu da kolera salgınlarının daha hızlı yayılmasına neden olabilir.
- Seyahat ve Turistik Faaliyetler: Seyahat eden kişiler aracılığıyla da yayılabilir. Turistik bölgelerde hijyen standartlarının düşük olması veya kontamine gıdaların tüketilmesi seyahat edenlerin enfekte olma riskini artırabilir.
- Aşı Eksikliği: Kolera aşıları hastalığa karşı koruma sağlar. Bu aşıların eksikliği kolera enfeksiyonuna karşı savunmasızlık yaratabilir.
- Zayıf Bağışıklık Sistemi: Zayıf bağışıklık sistemine sahip bireyler enfeksiyona karşı daha savunmasızdır. Kronik hastalıkları olan veya bağışıklık sistemleri baskılanmış olan kişiler kolera riski altındadır.
- Endemik Bölgelerde Yaşamak: Kolera özellikle endemik olarak bilinen bölgelerde daha yaygındır.
Kolera Belirtileri Nelerdir?
Kolera özellikle sıvı kaybı ve elektrolit dengesizliğiyle ilişkilendirilen belirgin bulgularla tanınır. Bu belirtiler hastalığın vücuda etkilerinin bir sonucu olarak ortaya çıkar. Kolera belirtileri şunlardır:
- Sulu İshal: İshal, genellikle sık ve bol miktarda sıvı dışkılama şeklinde başlar. Bu durum bağırsaklardan hızla sıvı kaybına yol açar ve vücutta dehidrasyona neden olur.
- Şiddetli Kusma: Şiddetli kusma nöbetleri ile karakterizedir. Bu kusmalar daha fazla sıvı kaybına katkıda bulunur ve vücuttaki elektrolit dengesizliğini artırır.
- Susuzluk: Vücutta ciddi bir susuzluk durumuna neden olur. Susuzluk, açlık hissi ve ağız kuruluğu ile kendini gösterir.
- Halsizlik ve Yorgunluk: Vücudu tükenmiş hissettirir. Hasta halsizlik, aşırı yorgunluk ve güçsüzlük yaşar.
- Kas Krampları: Elektrolit kaybı nedeniyle kas krampları gelişebilir. Bu kramplar ağrılı olabilir.
- Düşük Tansiyon ve Hızlı Nabız: Kolera enfeksiyonu düşük tansiyon ve hızlı nabız gibi dolaşım sorunlarına yol açabilir.
Kolera Nasıl Bulaşır?
Kolera özellikle hijyen eksikliği ve temiz içme suyu erişiminin sınırlı olduğu bölgelerde sık görülen bir bağırsak enfeksiyonudur. Bulaşma yolları aşağıdaki şekilde sıralanabilir:
- Kirli Su ve Su Kaynakları: Enfekte su kaynaklarından içilen su Vibrio cholerae bakterisinin insan vücuduna girişine yol açar. Bu, durum özellikle nehirler, göller ve su kuyuları gibi su kaynaklarıyla ilişkilidir.
- Kontamine Gıdalar: Kolera aynı zamanda kontamine gıdaların tüketilmesi ile de bulaşabilir. Özellikle yetersiz pişirilmiş veya kontamine gıdalar enfekte olmuş su veya su ürünleriyle temas ettiğinde kolera bakterilerini içerebilir. Tüketildiğinde bu gıdalar enfekte olmuş bakterileri vücuda taşıyabilir.
- Kişiden Kişiye Bulaşma: Enfekte kişilerin dışkıları hastalığın bulaşma kaynaklarından biridir. Kirli ellerin temizlenmemesi veya hijyen kurallarının ihmal edilmesi, kolera bakterilerinin kişiden kişiye geçmesine neden olabilir.
- Kanalizasyon ve Temizlik Uygulamaları: Kolera enfeksiyonunun yayılmasında kanalizasyon sistemlerinin eksikliği ve yetersiz temizlik uygulamaları da önemli bir rol oynar. Kirli suyun temiz içme suyu kaynaklarına karışması kolera salgınlarının başlangıcına yol açabilir.
- Kalabalık Ortamlar ve Yetersiz Sağlık Hizmetleri: Yoğun nüfusa sahip bölgelerde kolera salgını riski daha yüksektir. Sağlık hizmetlerinin yetersiz olduğu bölgelerde de hastalığın yayılma riski artabilir.
Kolera Tanısı Nasıl Konur?
Kolera tanısı genellikle hasta muayenesi ve laboratuvar testleri ile konur. Doktor hastanın semptomlarına ve tıbbi öyküsüne bakarak sürece başlar. Dışkı veya istifra edilen sıvının laboratuvar testleri, Vibrio cholerae bakterisinin varlığını tespit etmek için kullanılır. Aynı zamanda hastanın sıvı kaybı ve elektrolit seviyeleri de kan testleriyle değerlendirilir. Kolera tanısı klinik belirtilerle laboratuvar sonuçlarının birleşimine dayanır. Hızlı tanı ve tedavi hastanın iyileşme şansını artırabilir, bu nedenle şüpheli bir durumda bir sağlık profesyoneline başvurmak önemlidir.

Kolera Tedavisi Nasıl Yapılır?
Kolera tedavisi enfeksiyonun kontrolü ve hastanın iyileşmesini amaçlayan bir dizi önlemi içerir. Kolera tedavisi için uygulanabilen yöntemler şunlardır:
- Sıvı ve Elektrolit Tedavisi: Kolera vücuttan büyük miktarda sıvı ve elektrolit kaybına neden olur. Tedavinin temel bileşeni kaybedilen sıvı ve elektrolitlerin yerine konmasıdır. Özellikle oral rehidrasyon solüsyonları (ORS) hastaların sıvı kaybını dengelemek için kullanılır. ORS su, tuz ve şeker karışımını içerir ve dehidrasyonu önler.
- Antibiyotik Tedavisi: Antibiyotikler kolera enfeksiyonunun şiddetini azaltabilir ve iyileşme sürecini hızlandırabilir. Fakat sıvı ve elektrolit tedavisi antibiyotik tedavisinden daha kritiktir ve bu nedenle hastaların öncelikle sıvı kaybını dengelemesi gerekir.
- İzolasyon ve Hijyen: Kolera hastaları hastalığın yayılmasını önlemek amacıyla izole edilmelidir. Hastayla ve enfekte materyal ile temasın sınırlanması çevredeki insanlara enfeksiyon bulaşmasını önler. Temiz içme suyu sağlanmalı ve hijyen kurallarına sıkıca uyulmalıdır.
- Erken Müdahale: Kolera enfeksiyonu hızla ilerleyebilir ve dehidrasyon ciddi bir tehlike oluşturabilir. Bu nedenle erken teşhis ve tedavi çok önemlidir. Hasta, sıvı kaybını telafi etmek ve hastalığın şiddetini azaltmak için mümkün olan en kısa sürede tedaviye başlamalıdır.
- Aşı: Kolera aşısı hastalığa karşı koruma sağlar. Özellikle endemik bölgelerde yaşayanlar ve seyahat edenler için aşılar önerilebilir.
Sıkça Sorulan Sorular
Kolera, genellikle Vibrio cholerae adı verilen bir bakterinin neden olduğu bulaşıcı bir bağırsak enfeksiyonudur. Bu bakteri, kontamine su veya gıda yoluyla insanlara bulaşabilir ve sindirim sisteminde hasara neden olarak ciddi ishal ve dehidrasyona yol açabilir.
Kolera önlenebilir bir hastalıktır. Temiz içme suyuna erişim, hijyen kurallarına uymak, kontamine gıdalardan kaçınmak ve aşı olmak enfeksiyon riskini azaltabilir.
Kolera temiz suya ve hijyene erişimin sınırlı olduğu bölgelerde daha yaygındır. Özellikle gelişmekte olan ülkelerde ve doğal afet sonrası acil durumlarda kolera salgınları daha sık görülür.
İlişkili Branşlar
Tümünü Gör



















